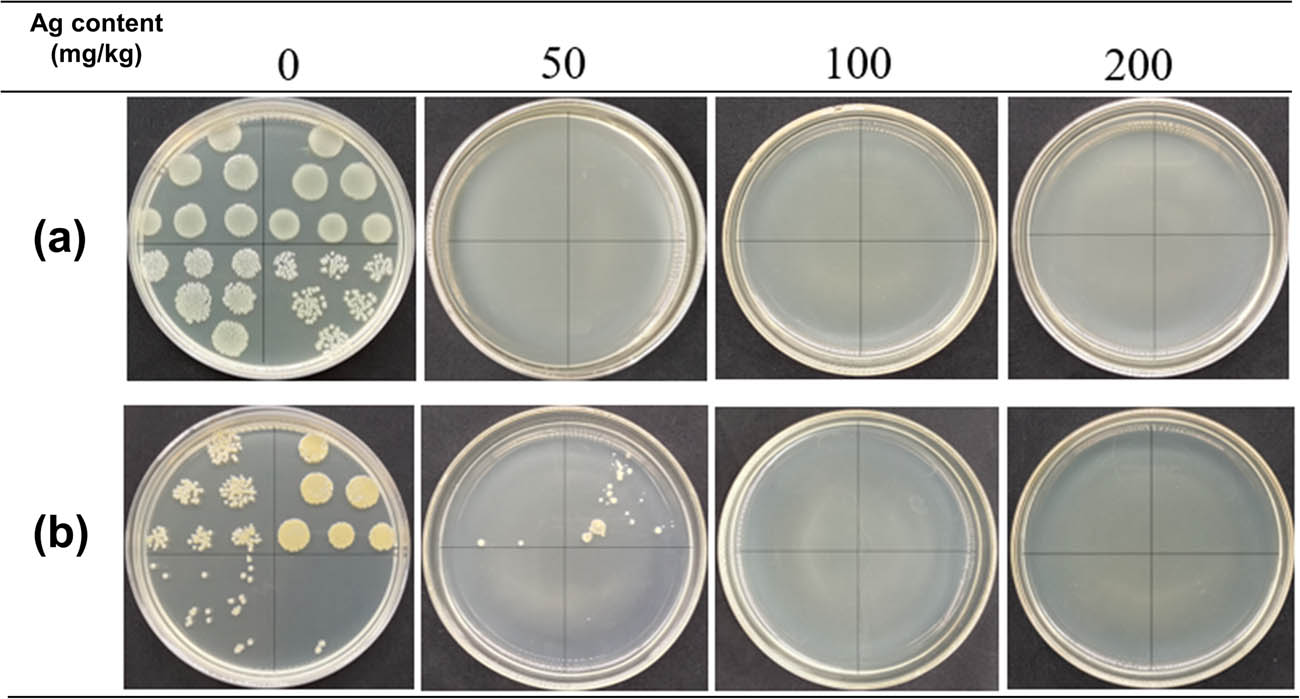
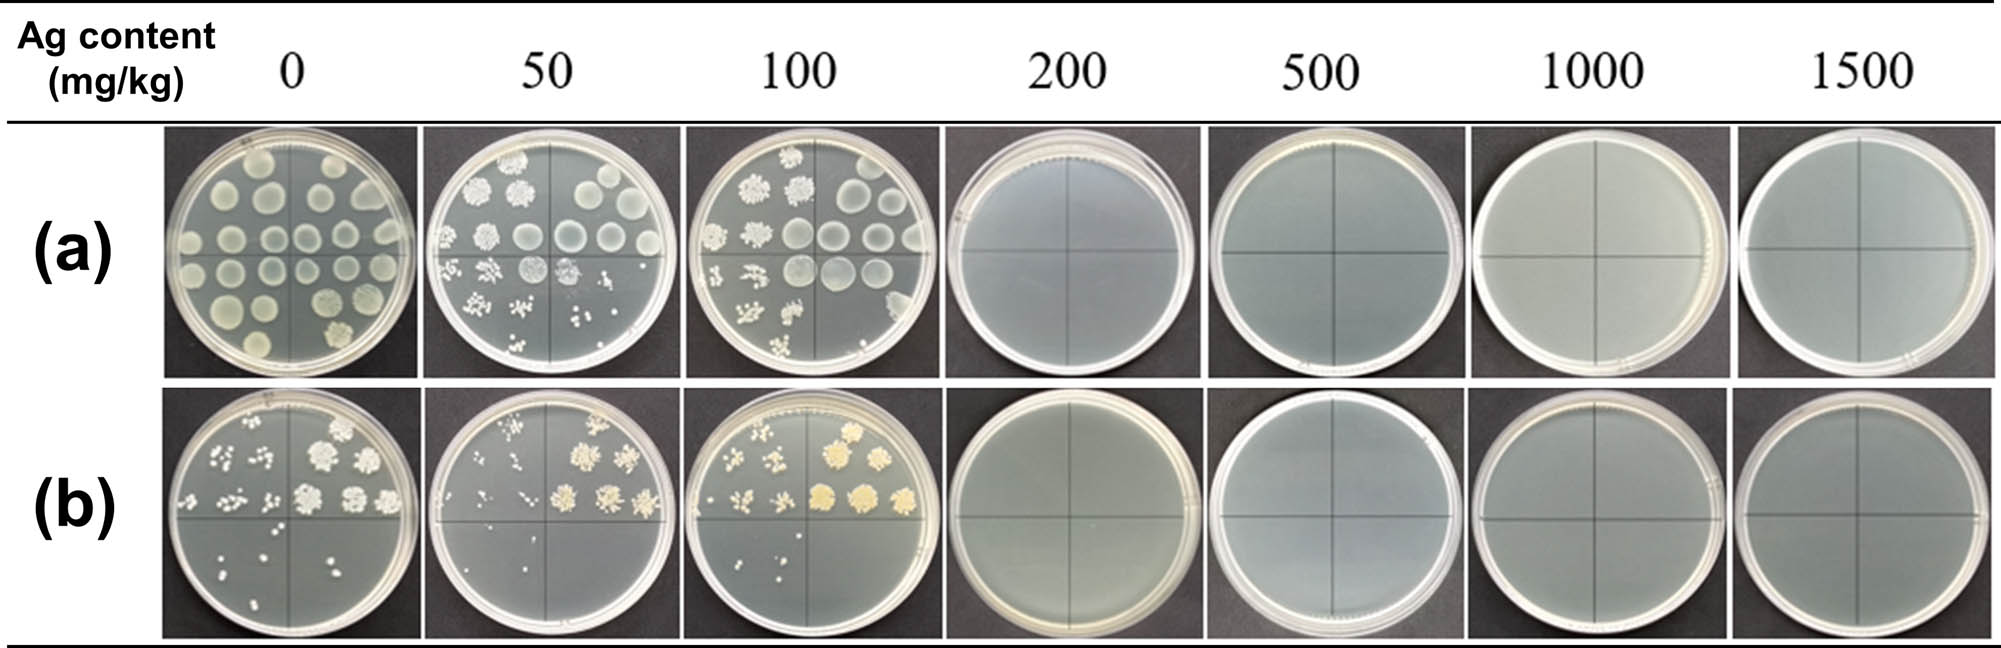

Abstract
The clean production and washing resistance of nano-coating have always been common issues in nano-functional polyester textiles because of the dense structure and chemically inert surface. Here, we developed a clean treatment strategy for preparing washable silver nanoparticle (AgNP)-coated polyester fibers through high-temperature, high-pressure hydrothermal self-assembly of AgNPs in polyester fibers. AgNPs with high affinity to polyester were prepared through the hydrothermal reduction of AgNO3 by hyperbranched poly(amide-amine)s. The as-prepared spherical AgNPs possessed a uniform particle size (∼7.52 nm), a positive charge (zeta potential of +54.52 mV), and good dispersibility and chemical stability at 110–130°C. The optimal clean treatment conditions had Ag concentrations of 1–50 mg/L, impregnation time of 2 h, and impregnation temperature of 110°C. Therefore, the Ag content of polyester fibers in the range 0–2,500 mg/kg could be precisely controlled. The as-prepared polyester fibers exhibited excellent antibacterial activities and washing resistance and low Ag release (0.00024% for 24 h). Even when the Ag content was as low as ∼50 mg/kg, the corresponding bactericidal rates increased to 99.99% for Escherichia coli and 99.93% for Staphylococcus aureus. The sample containing ∼200 mg/kg of Ag could achieve up to a 99.99% bactericidal rate for E. coli and 99.9% for S. aureus even after 50 standard washes.
1 Introduction
With the growing demand for human health, antibacterial textiles have become increasingly important in clothing and home textiles because they combat microorganism transmission and microorganism-related diseases. Among numerous antibacterial materials, silver nanoparticles (AgNPs) are promising antibacterial agents because of their incomparable antibacterial properties including robust and broad-spectrum antimicrobial activities, low bacterial resistance, good physical and chemical stability, and good biosafety [1]. However, current top-down functionalization strategies for AgNP-coated fibers, especially polyester fibers, face multiple risks such as serious nano-wastewater pollution, low oxidation resistance, and weak bonding fastness to fabrics, resulting in poor functional durability, uncontrollable Ag content, and/or incompatibility with the existing textile finishing process because of the lack of high chemical stability and sufficient affinity to polyester [2,3,4]. Therefore, the development of a clean and Ag content-controllable bottom-up preparation approach for washable antibacterial AgNP-coated fibers based on traditional textile finishing equipment is the key for meeting industrial production and environmental protection requirements.
At present, only a few processes can realize clean production or a washable function, let alone both. Several researchers have developed a clean vacuum evaporation or sputtering process to coat fibers [5]. However, naked Ag coating easily oxidizes and peels off from fiber surfaces under washing action. Nevertheless, the dyeing process of polyester with disperse dyes provides a feasible solution to this issue. Disperse dyes containing polar groups, such as amino groups, can completely self-assemble in the interior of polyester fibers under a high-temperature, high-pressure hydrothermal environment, thereby achieving clean production and good washability. Dye molecules can penetrate into the amorphous region of the fibers through the micro-cracks generated by strong fiber swelling when the dyeing temperature exceeds the glass transition temperature of polyester fibers [6]. However, the following important properties are required for the self-assembly of AgNPs to polyester: good water solubility to endow NPs with a high degree of freedom, excellent oxidation resistance, and high-temperature resistance to adapt to the high-temperature finishing process of polyester fibers, and strong chemical affinity to the fabric to ensure high assembly efficiency and washing resistance. Integrating these properties requires the modification of NP surfaces with a reactive capping macromolecule with high affinity to polyester. Such a macromolecule can introduce self-reduction and electrosteric repulsion among NPs, thereby providing high oxidation resistance and solution stability [7,8]. Considering that polyester has a certain negative charge, positively charged amino-functionalized AgNPs with self-reducibility and the capability to form electrostatic and hydrogen bonding interactions with polyester macromolecules are ideal candidates [9,10,11,12,13,14].
However, traditional linear cationic polymers have the defect of intermolecular and intramolecular entanglement in water, which greatly reduces the density of surface-active groups and weakens the degree of freedom of NPs [15]. By contrast, amino-terminated hyperbranched poly(amide-amine)s (HBPAAs) possess numerous vital advantages, including strong intermolecular repulsion, a three-dimensional cavity structure with an excellent volume restriction effect, strong reduction with a positive correlation with temperature that prevents NPs from oxidation in a high-temperature hydrothermal environment, a positive surface charge, abundant amino surface groups to impart NPs with high physico-chemical affinities to polyester fibers, and good microbial adsorption and killing performance [16,17]. With the assistance of high temperature and pressure, water-soluble HBPAA-capped AgNPs can self-assemble on the surface and the inside of polyester fibers when the intra-fiber micro-cracks are opened and enlarged. After treatment, the fiber interstitial space is reclosed, thereby encapsulating AgNPs inside the fibers. To summarize, due to the intermolecular forces between HBPAA and polyester and hydrothermal osmotic pressure, HBPAA-capped AgNPs can efficiently self-assemble on polyester fibers. A low Ag content can achieve ultra-high antibacterial properties because AgNPs and HBPAA have good antibacterial properties, thereby making the clean self-assembly of AgNPs possible.
On the basis of the above analysis, to solve the problems in the clean preparation and washing resistance of AgNP-coated polyester fibers, we used hydrothermal self-assembly technology to completely self-assemble AgNPs on the surface and in the inner amorphous area of fibers under strong electrostatic and hydrogen bonding interactions and high osmosis pressure. To achieve these objectives, we designed HBPAA-capped AgNPs with a good self-reducing capability against oxidation resistance under 100–130°C, high solution stability, low NP entanglement, and high fiber affinity to endow NPs with a spontaneous adsorption capability for polyester fibers. HBPAA-capped AgNPs were synthesized through the hydrothermal reduction of Ag+ by HBPAA without any additional reductants or protectants. The physical properties, high-temperature resistance, and self-reduction of as-prepared AgNPs were studied. In addition, the self-assembly behavior of HBPAA-capped AgNPs on polyester fibers in nano-Ag solution was investigated to determine the complete adsorption conditions. Then, the antibacterial activities, washing fastness, and Ag release property of AgNP-coated polyester fibers in simulated sweat were evaluated.
2 Experiment
2.1 Materials
Polyester fibers were obtained from the Zhangjiagang Nellnano Technology Co., Ltd (Suzhou, China). HBPAAs were synthesized through the use of our previous reported method [18]. AgNO3 (>99.8%), HNO3 (65–68%), and HCl (36–38%) were received from Sinopharm Chemical Reagent Co., Ltd (Shanghai, China). Gram-negative Escherichia coli (ATCC 25922) and Gram-positive Staphylococcus aureus (CMCC 26003) were obtained from the Shanghai Luwei Technology Co., Ltd (Shanghai, China). Nutrient agar and broth were purchased from the Shanghai Zhongke Insect Biotechnology Development Co., Ltd (Shanghai, China). Phosphorus-free Economic Commission for Europe (ECE) detergent was ordered from the Xiangda Instrument Co., Ltd (Dongguan, China).
2.2 Synthesis of HBPAA-capped AgNPs
HBPAA-capped AgNPs were synthesized by using our previously reported method with certain modifications. AgNO3 (20 mg, 0.078 mmol) was dissolved in water under vigorous stirring. Then, HBPAA (19.7 mg, 0.050 mmol) was added, and the solution turned from a colorless transparent solution to a yellowish liquid. The above solution was then heated to 98°C under infrared light irradiation in a programmable infrared dyeing machine and was kept at this temperature for 1 h. The resultant black-colored solution was stored in a brown bottle.
To verify the inoxidizability of AgNPs at ultra-high temperatures (110–130°C), the aqueous solution of AgNO3 and HBPAA (Ag element concentration: 10 mg/L) was treated at 110, 120, and 130°C for 2 h to prove the reducibility of HBPAA. In addition, 10 mg/L of HBPAA-capped AgNPs were heated to 110, 120, and 130°C and then held for 2 h. The changes in the color and ultraviolet-visible (UV-Vis) spectra of AgNPs were analyzed.
2.3 Hydrothermal self-assembly of AgNPs to polyester fibers
A single factor analysis experiment was used to explore the influence of Ag concentration, time, and temperature on the self-assembly of AgNPs on polyester fibers. Polyester fibers (1 g) were immersed in 50 mL of the nano-Ag solution at concentrations ranging from 1 to 50 mg/L and then transferred to an infrared dyeing machine. The temperature was increased stepwise through the temperature control system to a set temperature (90–130°C) and then was maintained at that level for 1–3 h. The volume of polyester fibers expanded dramatically under high-temperature and high-pressure hydrothermal conditions, which created many pores and passages where the AgNPs could enter. Finally, AgNP-coated polyester fibers were collected, dried at 60°C, and then stored in the sample bags. The remaining Ag concentration in the solution was measured by an inductively coupled plasma source mass spectrometer (ICP-MS). The Ag content of the treated polyester fibers was then calculated by our previous reported method [19].
2.4 Characterization
The morphological structure and distribution of the AgNPs were observed using a transmission electron microscope (TEM; JEOL 2100F, Japan) at an acceleration voltage of 120 kV. The absorbance and concentration of the nano-Ag solution were measured by a UV spectrophotometer (UV-vis; TU-1901, Beijing Puxi General Instrument Co., Ltd, China). The zeta potential and particle size of the AgNPs were measured by a Zetasizer (90 plus Zeta, Brookhaven instruments corporation, USA). Fourier transform infrared (FTIR; Thermo Nicolet iS50, USA) spectroscopy was used to determine the chemical construction of polyester fibers. The surface morphologies of the polyester fibers were observed using a field emission scanning electron microscope (SEM; Gemini SEM 300, Carl Zeiss, Germany). The chemical composition of the polyester fibers was analyzed by X-ray photoelectron spectroscopy (XPS, Thermo Scientific K-Alpha+, USA). The thermal property of the polyester fibers was investigated by thermogravimetric analysis (TG; TG209F3, NETZSCH, Germany), in which the fibers were heated from 30 to 800°C under a nitrogen atmosphere at a heating rate of 40°C/min. The Ag concentration in the aqueous solution was detected by ICP-MS (PerkinElmer NexION 350, USA).
2.5 Antimicrobial test
The modified oscillation method (GB/T 20922.3-2008, China) was used to test the antibacterial properties of polyester fibers. Gram-negative E. coli (ATCC 25922) and Gram-positive S. aureus (CMCC 26003) were selected as the test strains. Before each assay, the glassware, nutrient broth, and nutrient agar used in the experiment were sterilized at 121°C for 20 min in a sterilization pot. Bacteria were cultured in the nutrient broth with shaking at 130 rpm for 18–20 h and then diluted to 3–5 × 104 colony forming units (CFU)/mL in 0.03 M of phosphate-buffered saline. The fiber samples were pre-sterilized with UV light for 30 min and then placed in a sterile Erlenmeyer flask containing 70 mL of 0.03 M phosphate buffer and 5 mL of diluted bacterial solution. Then, they were shaken at 130 rpm at 37°C for 15 h. The nutrient agar (∼15 mL) was poured into the Petri dish. After cooling and solidification, 1 mL of the diluted bacterial solution was evenly smeared on the culture medium and cultured in a biochemical incubator at 37°C for 24 h. Finally, 100 μL of the bacterial suspension was obtained, serially diluted with saline (×101, ×102, and ×103), transferred onto LB agar, and then incubated at 37°C for 24 h. The percentage reduction (cfu, %) was calculated as follows:
where C and A are the bacterial colonies of the blank and treated fibers. All antibacterial experiments were performed in triplicate with three substrates, and mean values were calculated. Differences among the groups were analyzed with one-way analysis of variance followed by the least-significant difference test using SPSS 20.0; p < 0.05 was considered significant.
2.6 Washability test
The washing fastness of the polyester fibers was measured according to the GB/T 12490-2014 standard test method No. AS1 (China).
3 Results and discussion
The HBPAA-capped AgNPs were prepared by the improved method previously reported by our group. AgNO3 was reduced by HBPAA without any additives in water through a hydrothermal reaction by infrared thermal radiation heating instead of electrical resistance trace heating to restrain the uneven particle size caused by excessive local temperature. All HBPAA-capped AgNPs possessed spheroidal morphology with a uniform diameter in the range of 3–14 nm (Figure 1a). As shown in Figure 1b, AgNPs showed linear edges and clear lattice fringes inside and on the edge, indicating a relatively complete crystal structure. The lattice spacing of AgNPs shown in Figure 1b was 0.24 nm, which was consistent with the (111) crystal plane spacing of metallic Ag. The good chemical stability came from the encapsulation effect and high reducibility of HBPAA, which inhibited the oxidation of AgNPs. Figure 1a shows the size distribution of AgNPs. The proportion of AgNPs with diameters of 3–5, 5–8, 9–14, and 15–100 nm accounted for about 9.4, 63, 26.1, and 1.4%, respectively. The mean average diameter was about 7.52 nm, and AgNPs with diameters of 3–14 nm accounted for 98.5% of the total. These suggested that the particle size was around 10 nm, consistent with the observed morphology distribution from TEM images. The zeta potential of the nano-Ag solution is shown in Figure 1b. AgNPs were encapsulated inside the amino-terminated nano-cavity structured HBPPAA. Thus, the surface physical and chemical properties of AgNPs, such as surface potential and chemical stability, were determined by the huge number of surface amino groups. As shown in Figure 1d, the surface potential of AgNPs was approximately +54.52 mV. The positively charged nature came from amino cationization on the surface of HBPAA. The HBPAA on the surface of AgNPs endowed the NP surface with two other advantages, namely, excellent chemical stability of AgNPs, which was derived from the high reducibility of HBPAA, and high chemical affinity toward negatively charged fiber materials. The AgNPs were prepared by the reduction of AgNO3 by HBPAA in water in the absence of additional reducing agents. The reduction rate increased with increasing temperature. This finding indicated that the oxidation of AgNP and Ag ion release can be inhibited by reductive HBPAA, especially at high temperature. The generation of metallic AgNPs was evidenced by UV-Vis spectra. As shown in Figure 1e, AgNPs had a typical characteristic absorption peak at 407 nm in the UV-vis light range (350–480 nm). In addition, the intensity of the absorption peak of AgNPs at 407 nm had a linear positive correlation with the concentration of AgNPs when the concentration range was 10–20 mg/L. This law can be applied to calculate the concentration of AgNPs by UV-Vis spectrophotometry.

(a and b) TEM images, (c) particle size distribution, (d) UV-vis spectra, and (e) zeta potential of AgNPs. (f) Linear fitting curve of Ag concentration and the corresponding UV-vis absorbance (407 nm). (g) Photos and (h) UV-vis spectra of nano-Ag solution (10 mg/L) after treatment at different temperatures for 2 h. (i) Photos of the mixture of AgNO3 and HBPAA after treatment at different temperatures for 2 h. The corresponding Ag content was 10 mg/L, and the mass ratio of Ag to HBPAA was the same as the as-prepared nano-Ag solution.
The reducibility of HBPAA was important for maintaining the good chemical stability of AgNPs. AgNO3 was quickly reduced by HBPAA in water at nearly 100°C without any additional reducing agents because HBPAA shows strong reducibility at high temperatures. In addition, when the temperature was raised to 110, 120, and 130°C, the color and absorbance intensity of the UV-vis spectra of the AgNPs remained unchanged. The AgNO3 in the mixture of AgNO3 and HBPPA was reduced to AgNPs due to the reducibility of HBPAA (Figure 1g–i). This result indicates that the AgNPs possessed high chemical stability at high temperatures probably because the oxidized AgNPs, that is, Ag+, were prone to be re-reduced to AgNPs by HBPAA (Figure 1i). In addition, AgNO3 was only partially reduced to AgNPs at room temperature, suggesting that HBPAA was more reductive at high temperatures (110–130°C) than at low temperatures. Compared to conventional AgNPs, which were prone to oxidize at high temperatures, the as-prepared AgNPs exhibited excellent oxidation resistance at high temperatures, thus providing a performance guarantee for subsequent hydrothermal treatment.
Polyester fibers contain a benzene ring and an aliphatic chain in the main chain and two carbonyl side groups. Thus, they are highly chemically inert, and additional strong binding forces should be used to overcome the thermal entropy of AgNPs except electrostatic adsorption and hydrogen bonding. A high-temperature and high-pressure hydrothermal treatment was developed. This process could significantly expand the fiber and open the channel in the amorphous region, thereby allowing NPs to penetrate into the interior through high osmotic pressure (Figure 2). The hydrothermal self-assembly behavior of NPs was very similar to polyester dyeing, which was determined by the concentration of AgNPs, solution temperature, and treatment time. Figure 3a shows the Ag concentration-dependent self-assembly capacity and efficiency of AgNPs on fiber surface. When the concentration was below 5 mg/L, the adsorption efficiency of AgNPs in polyester fibers was approximately 96.6%. This value further increased to approximately 99.3 and 99.7% by increasing the concentration of AgNPs from 5 to 50 mg/L. Figure 3b shows that the solution temperature had a significant influence on the assembly of AgNPs on polyester especially when the temperature increased to a level above the boiling point. With increasing heating temperature from 30 to 110°C, the assembly efficiency of the polyester increased from approximately 77.43% to approximately 99.7% because of strong fiber swelling. Further, the increase in temperature from 110 to 130°C led to a light decrease in assembly efficiency, probably because AgNPs gradually became unstable at very high temperature. The time-dependent assembly efficiency of AgNPs in fibers showed that the adsorption reached equilibrium after 2 h of impregnation. Electrostatic adsorption and hydrogen bond interaction among amino groups on the surface of the AgNPs and polyester dominate the self-assembly behavior, whereas osmotic pressure overwhelm intermolecular forces when the temperature exceeded the boiling point of water. Notably, AgNPs showed high temperature resistance and good dispensability in water during the treatment because of the high reducibility of HBPAA. To save energy, the optimal clean treatment condition was set at a solution temperature of 110°C, treatment time of 2 h, and Ag concentration of 50 mg/L.

Schematic representation of the self-assembly of HBPAA-capped AgNPs on polyester fiber surfaces in a high-temperature and high-pressure hydrothermal environment.

Adsorption of AgNPs by polyester fibers as a function of (a) impregnation concentration (impregnation temperature: 110°C; impregnation time: 2 h), (b) impregnation temperature (impregnation concentration: 10 mg/L; impregnation time: 2 h), and (c) impregnation time (impregnation concentration: 10 mg/L; impregnation temperature: 110°C). (d) Photos of the residual solution of AgNPs after AgNPs were adsorbed by polyester fibers.
Figure 4 shows the FTIR spectra of polyester fibers. Pure polyester showed characteristic peaks at 3328.3 (combined water absorption peak), 2854.7 (C–H stretching vibrations), 1,704 (C═O stretching vibrations), 1548.4 (the stretching vibration of C═C in the benzene ring), and 1237.3 cm−1 (the C–O stretching vibration of the ester group) [20]. Only HBPAA has infrared absorption activity in AgNPs. Thus, the mass only accounts for 0.5–2.5% of the total, and the functional finishing showed little changes in characteristic FTIR absorption peaks in polyester. Nevertheless, the HBPPA attachment can be directly observed in SEM. As shown in Figure 5a and b, the pure polyester fiber surface was smooth in micrometer scale and showed clear fibrous veins in nanoscale. However, after the treatment, the surface of AgNP-coated polyester fibers became very rough in the micrometer scale (Figure 5c). The adherent substance was composed of NPs and polymer films according to further amplification, thereby suggesting the attachment of HBPAA and AgNPs. The key evidence for the penetration of AgNPs into the fiber is shown in Figure 5e–g. FESEM images of the cross-section of the coated polyester fiber indicated that numerous NPs were found inside the fiber, and these were proven to be HBPAA-capped AgNPs by energy dispersive X-ray spectrometry (EDS) analysis.

FTIR spectra of (black) pure and (red) treated polyester fibers and (blue) HBPAA.

SEM images of (a and b) pure polyester fibers, the (c and d) longitudinal and (e and f) cross sections of AgNP-coated polyester fibers, and the (g) EDS spectra of coated polyester fibers. To observe the cross-section of fibers, polyester fibers were combed into bundles, cut by a slicer, and pasted on the vertical sample table by the conductive tape.
The chemical compositions of pure and coated polyester fibers were further assessed by XPS. Typical wide-scan spectra of pure and coated polyester fibers are shown in Figure 6a. The characteristic peaks of C1s and O1s for pure and coated polyester fibers were found at approximately 284 and 399 eV [21]. However, in Ag 3d XPS spectra, two metallic split Ag 3d signals were detected at approximately 373.8 and 367.8 eV in coated polyester fibers, whose distance was 6.0 eV in line with bulk metallic Ag [22]. In the C1s XPS signal, the relative content of C═O had slightly increased, and that of O–C═O had decreased compared to pure polyester, which could be due to the hydrogen bonding interaction between amide-rich HBPAA and polyester. Polyester is an N-free polymer. Thus, N1s XPS signals could directly reflect the molecular structure of HBPAA. As shown in Figure 6d, the deconvolution of N1s peak indicated that the N-containing groups in HBPAA composed amino and acylamide groups, which was in line with the molecular structure.

(a) Wide-scan, (b) Ag 3d, (c) C1s, and (d) N1s XPS spectra of pure and/or treated polyester fibers.
The thermal stability of metallic AgNPs was much higher than polyester in an oxygen-free environment. Thus, the thermal decomposition behavior of AgNP-coated polyester fibers was different from that of pure polyester. As shown in Figure 7, pure and coated polyester fibers underwent three weight-loss processes in the nitrogen atmosphere [23,24]. In the first stage, pure fibers, when the temperature increased from 30 to 378°C, and treated polyester fibers, when the temperature increased from 30 to 391°C, underwent small mass losses due to the loss of water. When temperature increased from 378 to 485°C, the pure polyester fibers started to degrade rapidly and released large amounts of gas, thereby resulting in rapid mass reduction, that is, 73.61% mass loss, and only 24% residue remained in this step. The corresponding epitaxial starting and termination temperatures were 378 and 485°C, respectively. In comparison, the corresponding temperature of coated polyester fibers increased to 391 and 497°C, respectively, indicating higher thermal stability. After passing through the high-speed decomposition stage, polyethylene terephthalate was almost converted to relatively stable solid carbides. The final mass loss of pure polyester fibers accounted for approximately 80%, and that of coated fibers accounted for approximately 79%. The mass discrepancy was due to the AgNPs.

(a) The TG curves of raw polyester fibers and treated polyester fibers. (b) The tensile stress of pure and AgNP-coated polyester fibers after 0 and 50 times of washing and that of the control sample treated by water under the same treatment conditions.
Notably, after treatment with HBPAA-capped AgNPs, only a slight decrease in fiber strength was observed. The tensile stress of the polyester fibers declined from 9.37 cN/dtex to 8.87 cN/dtex (5.3% loss), and that of the control sample treated by water declined to 6.52 cN/dtex (30.4% loss). This result indicates that the adsorption of HBPAA-capped AgNPs in the fibers could reduce the fiber damage by water probably because of the hydrogen bonding formed between the amino group in HBPAA and the terminal hydroxyl and carboxyl groups. Moreover, the carbonyl side group in polyester increased the structural integrity of the fiber when the HBPAA-capped AgNPs were adsorbed in the amorphous region. The tensile stress of the AgNP-coated polyester fibers washed for 50 times further decreased to 7.48 cN/dtex (i.e., 15.7% loss) when compared with the unwashed fibers, but it was still higher than that of the water-treated sample, suggesting that the loss of AgNPs led to mechanical degradation.
Considering the huge number of surface amino groups, the cationic HBPAA possessed excellent microbial adsorption and killing properties [25]. The synergistic effect of antibacterial HBPAA and AgNPs endowed the polyester fibers with excellent antibacterial activities. As shown in Table 1 and Figure 8, even when the Ag content was as low as ∼50 mg/kg, the CPU of the polyester fibers declined by more than six orders of magnitude for E. coli and by two orders of magnitude for S. aureus, with bactericidal rates of up to 99.99 and 99.93%, respectively. The corresponding inhibition rates were 99.999 and 99.93%, respectively. In addition, the antibacterial rates exhibited a positive correlation with the Ag content on fibers. When the Ag content was higher than 100 mg/kg, all samples reached 99.99% bactericidal rates for both E. coli and S. aureus. Antibacterial activities were possibly due to the presence of HBPAA at very low Ag content, whereas they were due to the dominant presence of AgNPs at high Ag content.
Antibacterial rates of the treated polyester fibers
| Ag content (mg/kg) | Antibacterial rates (%) | |
|---|---|---|
| Escherichia coli | Staphylococcus aureus | |
| ∼50 | 99.99 | 99.93 |
| ∼100 | 99.99 | 99.99 |
| ∼200 | 99.99 | 99.99 |
The antibacterial activity of AgNP-coated polyester fibers against (a) Escherichia coli and (b) Staphylococcus aureus.
A portion of the HBPAA-capped AgNPs was encapsulated inside the polyester fibers due to the hydrothermal osmosis process, which resulted in good washing resistance. As shown in Figure 9, all fiber samples faded in color after washing for 50 times. Polyester fibers with an Ag content of 50–200 mg/kg were almost washed to white. Nevertheless, polyester fibers with an Ag content of 200 mg/kg reached up to 99.99% bactericidal rates for E. coli and 99.99% for S. aureus even though the fibers lost the bactericidal action at 50 and 100 mg/kg (Table 2 and Figure 10). This finding indicated that a considerable proportion of AgNPs was probably hidden in the fiber amorphous region. In addition, HBPAA contributed to good washing durability. Given that HBPAA has a positive charge and abundant amino terminate groups, when HBPAA-capped AgNPs were adsorbed on the polyester fibers, HBPAA could stick AgNPs on the fibers under intermolecular hydrogen bonding and electrostatic forces. Meanwhile, reductive HBPAA can prevent AgNPs from oxidizing, thus reducing the chemical dissolution of AgNPs. As shown in Figure 9, the polyester fibers treated with 500, 1,000, and 1,500 mg/kg of AgNPs had a faded yellow color, indicating a certain proportion of AgNPs loaded on the surface of the fiber. Similarly, the antibacterial activities of AgNP-coated polyester fibers exhibited positive correlation with the Ag content. Coated polyester fibers possessed much better antibacterial activities against E. coli than S. aureus. In consideration of wash fastness, the optimal Ag content of polyester fibers was set as ∼500 mg/kg. The above hydrothermal treatment study showed that fibers with Ag contents up to ∼2,500 mg/kg could be fabricated by a nearly complete adsorption process, which was far beyond the requirements for washing resistance. To assess the amount of Ag released from the AgNP-coated fibers in a sweat environment, AgNP-coated fibers were impregnated in simulated sweat for 24 h, and the released Ag content was tested (Figure 9). The detected Ag content in the impregnation solution was only 0.048 mg/L, that is, 0.0024 mg (0.00024% of the total Ag) of Ag released from fibers. Such a negligible Ag release suggests good biosafety. This negligible release is probably due to the good chemi-physical stability and strong adhesion of HBPPA-capped AgNPs to polyester. To summarize, although some AgNPs were washed off after 50 times of washing, the released amount of Ag in sweat was lower than the upper limit of Ag in tap water (Figure 9).

(a) Original and (b) washed polyester fibers and (c) photos of the process of impregnation of 1 g of AgNP-coated polyesters fibers in 50 mL of simulated sweat. The detected Ag content by the ICP-MS method in the final impregnation solution was 0.048 mg/L.
Antibacterial rate of treated polyester fibers after laundering for 50 cycles
| Ag content (mg/kg) | Antibacterial rates (%) | |
|---|---|---|
| Escherichia coli | Staphylococcus aureus | |
| ∼50 | — | 96.90 |
| ∼100 | — | 97.59 |
| ∼200 | 99.99 | 99.99 |
| ∼500 | 99.99 | 99.99 |
| ∼1,000 | 99.99 | 99.99 |
| ∼1,500 | 99.99 | 99.99 |
The antibacterial results against (a) Escherichia coli and (b) Staphylococcus aureus of the treated polyester fibers after laundering for 50 cycles.
4 Conclusion
Positively charged HBPAA-capped AgNPs with an average grain size of 7.52 nm were successfully prepared through an improved infrared light irradiation-driven hydrothermal reduction. The as-prepared AgNPs maintained good chemi-physical stability even in a 110–130°C hydrothermal environment. Depending on the affinity of polymers to fibers and high osmosis pressure, up to 50 mg/L of AgNPs could be completely assembled on polyester fibers at 110°C after 2 h of impregnation, which corresponded to 2,500 mg/kg of Ag content. The AgNP-coated polyester fibers showed good mechanical properties (maintained 94.7% of the original tensile stress, which is much higher than that treated by water), excellent antibacterial property (99.9% bactericidal rates for E. coli and S. aureus with a Ag content of as low as 50 mg/kg), excellent washing resistance (99.99% bactericidal rates for E. coli and S. aureus under 50 times of washing with a Ag content of as low as 500 mg/kg), nearly negligible Ag release (0.00024% of the total Ag for 24 h), and controllable Ag content (0–2,500 mg/kg). Such a preparation strategy is compatible with the existing dyeing process and can achieve clean production of washable AgNP-coated polyester fibers. Hence, it could provide a new route for clean, mass production of durable antibacterial polyester fibers.
-
Funding information: The authors acknowledge the financial support of the China Postdoctoral Science Foundation (No. 2020M671580), the National Natural Science Foundation of China (Young Foundation) (No. 51703098), Jiangsu Province Industry–University–Research Cooperation Project (China) (No. BY2020540), the Nantong science and technology research project (China) (MS12020050, MS12020051), Research Project of Jiangsu Advanced Textile Engineering Technology Center (XJFZ/2021/6), and the Fiber materials research project for the emergency protection and public safety of Shenghong Group (China).
-
Author contributions: All authors have accepted responsibility for the entire content of this manuscript and have approved its submission.
-
Conflict of interest: The authors declare that they have no competing interests.
References
[1] Deshmukh SP, Patil SM, Mullani SB, Delekar SD. Silver nanoparticles as an effective disinfectant: a review. Mat Sci Eng C Mater. 2019;97:954–65.10.1016/j.msec.2018.12.102Search in Google Scholar PubMed PubMed Central
[2] Hebeish A, El-Naggar ME, Tawfik S, Zaghloul S, Sharaf S. Hyperbranched polymer–silver nanohybrid induce super antibacterial activity and high performance to cotton fabric. Cellulose. 2019;26(5):3543–55.10.1007/s10570-019-02319-xSearch in Google Scholar
[3] Zhang G, Wang D, Xiao Y, Dai J, Zhang W, Zhang Y. Fabrication of Ag Np-coated wetlace nonwoven fabric based on amino-terminated hyperbranched polymer. Nanotechnol Rev. 2019;8(1):100–6.10.1515/ntrev-2019-0009Search in Google Scholar
[4] Xu Q, Zheng W, Duan P, Chen J, Zhang Y, Fu F, et al. One-pot fabrication of durable antibacterial cotton fabric coated with silver nanoparticles via carboxymethyl chitosan as a binder and stabilizer. Carbohyd Polym. 2019;204:42–9.10.1016/j.carbpol.2018.09.089Search in Google Scholar PubMed
[5] Vale AC, Pereira PR, Barbosa AM, Torrado E, Alves NM. Optimization of silver-containing bioglass nanoparticles envisaging biomedical applications. Mat Sci Eng C-Mater. 2019;94:161–8.10.1016/j.msec.2018.09.027Search in Google Scholar PubMed
[6] Qiu J, Xiao J, Tang B, Ju B, Zhang S. Facile synthesis of novel disperse azo dyes with aromatic hydroxyl group. Dyes Pigments. 2019;160:524–9.10.1016/j.dyepig.2018.08.052Search in Google Scholar
[7] Tamayo L, Palza H, Bejarano J, Zapata PA. 8 – Polymer composites with metal nanoparticles: synthesis, properties, and applications. In: Pielichowski K, Majka TM. Polymer composites with functionalized nanoparticles. Elsevier; 2019. p. 249–86.10.1016/B978-0-12-814064-2.00008-1Search in Google Scholar
[8] Mayer M, Schnepf MJ, König TAF, Fery A. Colloidal self-assembly concepts for plasmonic metasurfaces. Adv Opt Mater. 2019;7(1):1800564.10.1002/adom.201800564Search in Google Scholar
[9] Kim E, Agarwal S, Kim N, Hage FS, Leonardo V, Gelmi A, et al. Bioinspired fabrication of DNA–inorganic hybrid composites using synthetic DNA. ACS Nano. 2019;13(3):2888–900.10.1021/acsnano.8b06492Search in Google Scholar PubMed PubMed Central
[10] Cho S-K, Cho S-J, Lee S-S, Choi K-H, Lee S-Y. DNA-directed amphiphilic self-assembly as a chemifunctional/multiscale-structuring strategy for high-performance Li–S batteries. J Mater Chem A. 2019;7(8):4084–92.10.1039/C8TA11398JSearch in Google Scholar
[11] Song J, He W, Shen H, Zhou Z, Li M, Su P, et al. Self-assembly of a magnetic DNA hydrogel as a new biomaterial for enzyme encapsulation with enhanced activity and stability. Chem Commun. 2019;55(17):2449–52.10.1039/C8CC09717HSearch in Google Scholar PubMed
[12] Soares SF, Fernandes T, Trindade T, Daniel-da-Silva AL. Trimethyl chitosan/siloxane-hybrid coated Fe3O4 nanoparticles for the uptake of sulfamethoxazole from water. Molecules. 2019;24(10):1958.10.3390/molecules24101958Search in Google Scholar PubMed PubMed Central
[13] Xiao J, Song W, Hu R, Chen L, Tian X. One-step arc-produced amino-functionalized graphite-encapsulated magnetic nanoparticles for the efficient removal of radionuclides. ACS Appl Nano Mater. 2019;2(1):385–94.10.1021/acsanm.8b01970Search in Google Scholar
[14] Louzi VC, JSdC Campos. Corona treatment applied to synthetic polymeric monofilaments (PP, PET, and PA-6). Surf Interfaces. 2019;14:98–107.10.1016/j.surfin.2018.12.005Search in Google Scholar
[15] Romo-Uribe A, Reyes-Mayer A, Paredes-Pérez M, Lichtenhan J, Yañez-Lino M, Sarmiento-Bustos E. POSS driven chain disentanglements, decreased the melt viscosity and reduced O2 transmission in polyethylene. Polymer. 2019;165:61–71.10.1016/j.polymer.2019.01.024Search in Google Scholar
[16] Mu B, Liu T, Tian W. Long-chain hyperbranched polymers: synthesis, properties, and applications. Macromol Rapid Comm. 2019;40(17):1800471.10.1002/marc.201800471Search in Google Scholar PubMed
[17] Gao L, Liu X, Xu M, Sun G, Xu S, Zou T, et al. Biodegradable anti-biofilm fiber-membrane ureteral stent constructed with a robust biomimetic superhydrophilic polycationic hydration surface exhibiting synergetic antibacterial and antiprotein properties. Small. 2021;17(20):2006815.10.1002/smll.202006815Search in Google Scholar PubMed
[18] Gao L, Wang Y, Li Y, Xu M, Sun G, Zou T, et al. Biomimetic biodegradable Ag@Au nanoparticle-embedded ureteral stent with a constantly renewable contact-killing antimicrobial surface and antibiofilm and extraction-free properties. Acta Biomater. 2020;114:117–32.10.1016/j.actbio.2020.07.025Search in Google Scholar PubMed
[19] Xu S, Zhang F, Yao L, Zhu C, Morikawa H, Chen Y. Eco-friendly fabrication of antibacterial cotton fibers by the cooperative self-assembly of hyperbranched poly(amidoamine)- and hyperbranched poly(amine-ester)-functionalized silver nanoparticles. Cellulose. 2017;24(3):1493–509.10.1007/s10570-016-1178-5Search in Google Scholar
[20] Zhou Y, Jiang L, Guo Y, Sun Z, Jiang Z, Chen S, et al. Rapid fabrication of silver nanoparticle/polydopamine functionalized polyester fibers. Text Res J. 2019;89(19–20):3968–78.10.1177/0040517519826893Search in Google Scholar
[21] Chen S, Zhang S, Galluzzi M, Li F, Zhang X, Yang X, et al. Insight into multifunctional polyester fabrics finished by one-step eco-friendly strategy. Chem Eng J. 2019;358:634–42.10.1016/j.cej.2018.10.070Search in Google Scholar
[22] Ma J, Wang X, Li J, Chen R, Wei J. Facile preparation of flame retardant cotton fabric via adhesion of Mg(OH)2 by the assistance of ionic liquid. Polymers. 2020;12(2):259.10.3390/polym12020259Search in Google Scholar PubMed PubMed Central
[23] Liu J, He H, Yu Z, Suryawanshi A, Li Y, Lin X, et al. Investigation of temperature-responsive and thermo-physiological comfort of modified polyester fabric with Sericin/PNIPAAm/Ag NPs interpenetrating polymer network hydrogel. Text Res J. 2020;90(23–24):2622–38.10.1177/0040517520931475Search in Google Scholar
[24] Chen Y, Liu S, Wan C, Zhang G. Facile synthesis of a high efficiency and durability L-citrulline flame retardant for cotton. Int J Biol Macromol. 2021;166:1429–38.10.1016/j.ijbiomac.2020.11.022Search in Google Scholar PubMed
[25] Trush M, Metelytsia L, Semenyuta I, Kalashnikova L, Papeykin O, Venger I, et al. Reduced ecotoxicity and improved biodegradability of cationic biocides based on ester-functionalized pyridinium ionic liquids. Environ Sci Pollut R. 2019;26(5):4878–89.10.1007/s11356-018-3924-8Search in Google Scholar PubMed
© 2021 Jundan Feng et al., published by De Gruyter
This work is licensed under the Creative Commons Attribution 4.0 International License.
Articles in the same Issue
- Research Articles
- Improved impedance matching by multi-componential metal-hybridized rGO toward high performance of microwave absorption
- Pure-silk fibroin hydrogel with stable aligned micropattern toward peripheral nerve regeneration
- Effective ion pathways and 3D conductive carbon networks in bentonite host enable stable and high-rate lithium–sulfur batteries
- Fabrication and characterization of 3D-printed gellan gum/starch composite scaffold for Schwann cells growth
- Synergistic strengthening mechanism of copper matrix composite reinforced with nano-Al2O3 particles and micro-SiC whiskers
- Deformation mechanisms and plasticity of ultrafine-grained Al under complex stress state revealed by digital image correlation technique
- On the deformation-induced grain rotations in gradient nano-grained copper based on molecular dynamics simulations
- Removal of sulfate from aqueous solution using Mg–Al nano-layered double hydroxides synthesized under different dual solvent systems
- Microwave-assisted sol–gel synthesis of TiO2-mixed metal oxide nanocatalyst for degradation of organic pollutant
- Electrophoretic deposition of graphene on basalt fiber for composite applications
- Polyphenylene sulfide-coated wrench composites by nanopinning effect
- Thermal conductivity and thermoelectric properties in 3D macroscopic pure carbon nanotube materials
- An effective thermal conductivity and thermomechanical homogenization scheme for a multiscale Nb3Sn filaments
- Friction stir spot welding of AA5052 with additional carbon fiber-reinforced polymer composite interlayer
- Improvement of long-term cycling performance of high-nickel cathode materials by ZnO coating
- Quantum effects of gas flow in nanochannels
- An approach to effectively improve the interfacial bonding of nano-perfused composites by in situ growth of CNTs
- Effects of nano-modified polymer cement-based materials on the bending behavior of repaired concrete beams
- Effects of the combined usage of nanomaterials and steel fibres on the workability, compressive strength, and microstructure of ultra-high performance concrete
- One-pot solvothermal synthesis and characterization of highly stable nickel nanoparticles
- Comparative study on mechanisms for improving mechanical properties and microstructure of cement paste modified by different types of nanomaterials
- Effect of in situ graphene-doped nano-CeO2 on microstructure and electrical contact properties of Cu30Cr10W contacts
- The experimental study of CFRP interlayer of dissimilar joint AA7075-T651/Ti-6Al-4V alloys by friction stir spot welding on mechanical and microstructural properties
- Vibration analysis of a sandwich cylindrical shell in hygrothermal environment
- Water barrier and mechanical properties of sugar palm crystalline nanocellulose reinforced thermoplastic sugar palm starch (TPS)/poly(lactic acid) (PLA) blend bionanocomposites
- Strong quadratic acousto-optic coupling in 1D multilayer phoxonic crystal cavity
- Three-dimensional shape analysis of peripapillary retinal pigment epithelium-basement membrane layer based on OCT radial images
- Solvent regulation synthesis of single-component white emission carbon quantum dots for white light-emitting diodes
- Xanthate-modified nanoTiO2 as a novel vulcanization accelerator enhancing mechanical and antibacterial properties of natural rubber
- Effect of steel fiber on impact resistance and durability of concrete containing nano-SiO2
- Ultrasound-enhanced biosynthesis of uniform ZnO nanorice using Swietenia macrophylla seed extract and its in vitro anticancer activity
- Temperature dependence of hardness prediction for high-temperature structural ceramics and their composites
- Study on the frequency of acoustic emission signal during crystal growth of salicylic acid
- Controllable modification of helical carbon nanotubes for high-performance microwave absorption
- Role of dry ozonization of basalt fibers on interfacial properties and fracture toughness of epoxy matrix composites
- Nanosystem’s density functional theory study of the chlorine adsorption on the Fe(100) surface
- A rapid nanobiosensing platform based on herceptin-conjugated graphene for ultrasensitive detection of circulating tumor cells in early breast cancer
- Improving flexural strength of UHPC with sustainably synthesized graphene oxide
- The role of graphene/graphene oxide in cement hydration
- Structural characterization of microcrystalline and nanocrystalline cellulose from Ananas comosus L. leaves: Cytocompatibility and molecular docking studies
- Evaluation of the nanostructure of calcium silicate hydrate based on atomic force microscopy-infrared spectroscopy experiments
- Combined effects of nano-silica and silica fume on the mechanical behavior of recycled aggregate concrete
- Safety study of malapposition of the bio-corrodible nitrided iron stent in vivo
- Triethanolamine interface modification of crystallized ZnO nanospheres enabling fast photocatalytic hazard-free treatment of Cr(vi) ions
- Novel electrodes for precise and accurate droplet dispensing and splitting in digital microfluidics
- Construction of Chi(Zn/BMP2)/HA composite coating on AZ31B magnesium alloy surface to improve the corrosion resistance and biocompatibility
- Experimental and multiscale numerical investigations on low-velocity impact responses of syntactic foam composites reinforced with modified MWCNTs
- Comprehensive performance analysis and optimal design of smart light pole for cooperative vehicle infrastructure system
- Room temperature growth of ZnO with highly active exposed facets for photocatalytic application
- Influences of poling temperature and elongation ratio on PVDF-HFP piezoelectric films
- Large strain hardening of magnesium containing in situ nanoparticles
- Super stable water-based magnetic fluid as a dual-mode contrast agent
- Photocatalytic activity of biogenic zinc oxide nanoparticles: In vitro antimicrobial, biocompatibility, and molecular docking studies
- Hygrothermal environment effect on the critical buckling load of FGP microbeams with initial curvature integrated by CNT-reinforced skins considering the influence of thickness stretching
- Thermal aging behavior characteristics of asphalt binder modified by nano-stabilizer based on DSR and AFM
- Building effective core/shell polymer nanoparticles for epoxy composite toughening based on Hansen solubility parameters
- Structural characterization and nanoscale strain field analysis of α/β interface layer of a near α titanium alloy
- Optimization of thermal and hydrophobic properties of GO-doped epoxy nanocomposite coatings
- The properties of nano-CaCO3/nano-ZnO/SBR composite-modified asphalt
- Three-dimensional metallic carbon allotropes with superhardness
- Physical stability and rheological behavior of Pickering emulsions stabilized by protein–polysaccharide hybrid nanoconjugates
- Optimization of volume fraction and microstructure evolution during thermal deformation of nano-SiCp/Al–7Si composites
- Phase analysis and corrosion behavior of brazing Cu/Al dissimilar metal joint with BAl88Si filler metal
- High-efficiency nano polishing of steel materials
- On the rheological properties of multi-walled carbon nano-polyvinylpyrrolidone/silicon-based shear thickening fluid
- Fabrication of Ag/ZnO hollow nanospheres and cubic TiO2/ZnO heterojunction photocatalysts for RhB degradation
- Fabrication and properties of PLA/nano-HA composite scaffolds with balanced mechanical properties and biological functions for bone tissue engineering application
- Investigation of the early-age performance and microstructure of nano-C–S–H blended cement-based materials
- Reduced graphene oxide coating on basalt fabric using electrophoretic deposition and its role in the mechanical and tribological performance of epoxy/basalt fiber composites
- Effect of nano-silica as cementitious materials-reducing admixtures on the workability, mechanical properties and durability of concrete
- Machine-learning-assisted microstructure–property linkages of carbon nanotube-reinforced aluminum matrix nanocomposites produced by laser powder bed fusion
- Physical, thermal, and mechanical properties of highly porous polylactic acid/cellulose nanofibre scaffolds prepared by salt leaching technique
- A comparative study on characterizations and synthesis of pure lead sulfide (PbS) and Ag-doped PbS for photovoltaic applications
- Clean preparation of washable antibacterial polyester fibers by high temperature and high pressure hydrothermal self-assembly
- Al 5251-based hybrid nanocomposite by FSP reinforced with graphene nanoplates and boron nitride nanoparticles: Microstructure, wear, and mechanical characterization
- Interlaminar fracture toughness properties of hybrid glass fiber-reinforced composite interlayered with carbon nanotube using electrospray deposition
- Microstructure and life prediction model of steel slag concrete under freezing-thawing environment
- Synthesis of biogenic silver nanoparticles from the seed coat waste of pistachio (Pistacia vera) and their effect on the growth of eggplant
- Study on adaptability of rheological index of nano-PUA-modified asphalt based on geometric parameters of parallel plate
- Preparation and adsorption properties of nano-graphene oxide/tourmaline composites
- A study on interfacial behaviors of epoxy/graphene oxide derived from pitch-based graphite fibers
- Multiresponsive carboxylated graphene oxide-grafted aptamer as a multifunctional nanocarrier for targeted delivery of chemotherapeutics and bioactive compounds in cancer therapy
- Piezoresistive/piezoelectric intrinsic sensing properties of carbon nanotube cement-based smart composite and its electromechanical sensing mechanisms: A review
- Smart stimuli-responsive biofunctionalized niosomal nanocarriers for programmed release of bioactive compounds into cancer cells in vitro and in vivo
- Photoremediation of methylene blue by biosynthesized ZnO/Fe3O4 nanocomposites using Callistemon viminalis leaves aqueous extract: A comparative study
- Study of gold nanoparticles’ preparation through ultrasonic spray pyrolysis and lyophilisation for possible use as markers in LFIA tests
- Review Articles
- Advance on the dispersion treatment of graphene oxide and the graphene oxide modified cement-based materials
- Development of ionic liquid-based electroactive polymer composites using nanotechnology
- Nanostructured multifunctional electrocatalysts for efficient energy conversion systems: Recent perspectives
- Recent advances on the fabrication methods of nanocomposite yarn-based strain sensor
- Review on nanocomposites based on aerospace applications
- Overview of nanocellulose as additives in paper processing and paper products
- The frontiers of functionalized graphene-based nanocomposites as chemical sensors
- Material advancement in tissue-engineered nerve conduit
- Carbon nanostructure-based superhydrophobic surfaces and coatings
- Functionalized graphene-based nanocomposites for smart optoelectronic applications
- Interfacial technology for enhancement in steel fiber reinforced cementitious composite from nano to macroscale
- Metal nanoparticles and biomaterials: The multipronged approach for potential diabetic wound therapy
- Review on resistive switching mechanisms of bio-organic thin film for non-volatile memory application
- Nanotechnology-enabled biomedical engineering: Current trends, future scopes, and perspectives
- Research progress on key problems of nanomaterials-modified geopolymer concrete
- Smart stimuli-responsive nanocarriers for the cancer therapy – nanomedicine
- An overview of methods for production and detection of silver nanoparticles, with emphasis on their fate and toxicological effects on human, soil, and aquatic environment
- Effects of chemical modification and nanotechnology on wood properties
- Mechanisms, influencing factors, and applications of electrohydrodynamic jet printing
- Application of antiviral materials in textiles: A review
- Phase transformation and strengthening mechanisms of nanostructured high-entropy alloys
- Research progress on individual effect of graphene oxide in cement-based materials and its synergistic effect with other nanomaterials
- Catalytic defense against fungal pathogens using nanozymes
- A mini-review of three-dimensional network topological structure nanocomposites: Preparation and mechanical properties
- Mechanical properties and structural health monitoring performance of carbon nanotube-modified FRP composites: A review
- Nano-scale delivery: A comprehensive review of nano-structured devices, preparative techniques, site-specificity designs, biomedical applications, commercial products, and references to safety, cellular uptake, and organ toxicity
- Effects of alloying, heat treatment and nanoreinforcement on mechanical properties and damping performances of Cu–Al-based alloys: A review
- Recent progress in the synthesis and applications of vertically aligned carbon nanotube materials
- Thermal conductivity and dynamic viscosity of mono and hybrid organic- and synthetic-based nanofluids: A critical review
- Recent advances in waste-recycled nanomaterials for biomedical applications: Waste-to-wealth
- Layup sequence and interfacial bonding of additively manufactured polymeric composite: A brief review
- Quantum dots synthetization and future prospect applications
- Approved and marketed nanoparticles for disease targeting and applications in COVID-19
- Strategies for improving rechargeable lithium-ion batteries: From active materials to CO2 emissions
Articles in the same Issue
- Research Articles
- Improved impedance matching by multi-componential metal-hybridized rGO toward high performance of microwave absorption
- Pure-silk fibroin hydrogel with stable aligned micropattern toward peripheral nerve regeneration
- Effective ion pathways and 3D conductive carbon networks in bentonite host enable stable and high-rate lithium–sulfur batteries
- Fabrication and characterization of 3D-printed gellan gum/starch composite scaffold for Schwann cells growth
- Synergistic strengthening mechanism of copper matrix composite reinforced with nano-Al2O3 particles and micro-SiC whiskers
- Deformation mechanisms and plasticity of ultrafine-grained Al under complex stress state revealed by digital image correlation technique
- On the deformation-induced grain rotations in gradient nano-grained copper based on molecular dynamics simulations
- Removal of sulfate from aqueous solution using Mg–Al nano-layered double hydroxides synthesized under different dual solvent systems
- Microwave-assisted sol–gel synthesis of TiO2-mixed metal oxide nanocatalyst for degradation of organic pollutant
- Electrophoretic deposition of graphene on basalt fiber for composite applications
- Polyphenylene sulfide-coated wrench composites by nanopinning effect
- Thermal conductivity and thermoelectric properties in 3D macroscopic pure carbon nanotube materials
- An effective thermal conductivity and thermomechanical homogenization scheme for a multiscale Nb3Sn filaments
- Friction stir spot welding of AA5052 with additional carbon fiber-reinforced polymer composite interlayer
- Improvement of long-term cycling performance of high-nickel cathode materials by ZnO coating
- Quantum effects of gas flow in nanochannels
- An approach to effectively improve the interfacial bonding of nano-perfused composites by in situ growth of CNTs
- Effects of nano-modified polymer cement-based materials on the bending behavior of repaired concrete beams
- Effects of the combined usage of nanomaterials and steel fibres on the workability, compressive strength, and microstructure of ultra-high performance concrete
- One-pot solvothermal synthesis and characterization of highly stable nickel nanoparticles
- Comparative study on mechanisms for improving mechanical properties and microstructure of cement paste modified by different types of nanomaterials
- Effect of in situ graphene-doped nano-CeO2 on microstructure and electrical contact properties of Cu30Cr10W contacts
- The experimental study of CFRP interlayer of dissimilar joint AA7075-T651/Ti-6Al-4V alloys by friction stir spot welding on mechanical and microstructural properties
- Vibration analysis of a sandwich cylindrical shell in hygrothermal environment
- Water barrier and mechanical properties of sugar palm crystalline nanocellulose reinforced thermoplastic sugar palm starch (TPS)/poly(lactic acid) (PLA) blend bionanocomposites
- Strong quadratic acousto-optic coupling in 1D multilayer phoxonic crystal cavity
- Three-dimensional shape analysis of peripapillary retinal pigment epithelium-basement membrane layer based on OCT radial images
- Solvent regulation synthesis of single-component white emission carbon quantum dots for white light-emitting diodes
- Xanthate-modified nanoTiO2 as a novel vulcanization accelerator enhancing mechanical and antibacterial properties of natural rubber
- Effect of steel fiber on impact resistance and durability of concrete containing nano-SiO2
- Ultrasound-enhanced biosynthesis of uniform ZnO nanorice using Swietenia macrophylla seed extract and its in vitro anticancer activity
- Temperature dependence of hardness prediction for high-temperature structural ceramics and their composites
- Study on the frequency of acoustic emission signal during crystal growth of salicylic acid
- Controllable modification of helical carbon nanotubes for high-performance microwave absorption
- Role of dry ozonization of basalt fibers on interfacial properties and fracture toughness of epoxy matrix composites
- Nanosystem’s density functional theory study of the chlorine adsorption on the Fe(100) surface
- A rapid nanobiosensing platform based on herceptin-conjugated graphene for ultrasensitive detection of circulating tumor cells in early breast cancer
- Improving flexural strength of UHPC with sustainably synthesized graphene oxide
- The role of graphene/graphene oxide in cement hydration
- Structural characterization of microcrystalline and nanocrystalline cellulose from Ananas comosus L. leaves: Cytocompatibility and molecular docking studies
- Evaluation of the nanostructure of calcium silicate hydrate based on atomic force microscopy-infrared spectroscopy experiments
- Combined effects of nano-silica and silica fume on the mechanical behavior of recycled aggregate concrete
- Safety study of malapposition of the bio-corrodible nitrided iron stent in vivo
- Triethanolamine interface modification of crystallized ZnO nanospheres enabling fast photocatalytic hazard-free treatment of Cr(vi) ions
- Novel electrodes for precise and accurate droplet dispensing and splitting in digital microfluidics
- Construction of Chi(Zn/BMP2)/HA composite coating on AZ31B magnesium alloy surface to improve the corrosion resistance and biocompatibility
- Experimental and multiscale numerical investigations on low-velocity impact responses of syntactic foam composites reinforced with modified MWCNTs
- Comprehensive performance analysis and optimal design of smart light pole for cooperative vehicle infrastructure system
- Room temperature growth of ZnO with highly active exposed facets for photocatalytic application
- Influences of poling temperature and elongation ratio on PVDF-HFP piezoelectric films
- Large strain hardening of magnesium containing in situ nanoparticles
- Super stable water-based magnetic fluid as a dual-mode contrast agent
- Photocatalytic activity of biogenic zinc oxide nanoparticles: In vitro antimicrobial, biocompatibility, and molecular docking studies
- Hygrothermal environment effect on the critical buckling load of FGP microbeams with initial curvature integrated by CNT-reinforced skins considering the influence of thickness stretching
- Thermal aging behavior characteristics of asphalt binder modified by nano-stabilizer based on DSR and AFM
- Building effective core/shell polymer nanoparticles for epoxy composite toughening based on Hansen solubility parameters
- Structural characterization and nanoscale strain field analysis of α/β interface layer of a near α titanium alloy
- Optimization of thermal and hydrophobic properties of GO-doped epoxy nanocomposite coatings
- The properties of nano-CaCO3/nano-ZnO/SBR composite-modified asphalt
- Three-dimensional metallic carbon allotropes with superhardness
- Physical stability and rheological behavior of Pickering emulsions stabilized by protein–polysaccharide hybrid nanoconjugates
- Optimization of volume fraction and microstructure evolution during thermal deformation of nano-SiCp/Al–7Si composites
- Phase analysis and corrosion behavior of brazing Cu/Al dissimilar metal joint with BAl88Si filler metal
- High-efficiency nano polishing of steel materials
- On the rheological properties of multi-walled carbon nano-polyvinylpyrrolidone/silicon-based shear thickening fluid
- Fabrication of Ag/ZnO hollow nanospheres and cubic TiO2/ZnO heterojunction photocatalysts for RhB degradation
- Fabrication and properties of PLA/nano-HA composite scaffolds with balanced mechanical properties and biological functions for bone tissue engineering application
- Investigation of the early-age performance and microstructure of nano-C–S–H blended cement-based materials
- Reduced graphene oxide coating on basalt fabric using electrophoretic deposition and its role in the mechanical and tribological performance of epoxy/basalt fiber composites
- Effect of nano-silica as cementitious materials-reducing admixtures on the workability, mechanical properties and durability of concrete
- Machine-learning-assisted microstructure–property linkages of carbon nanotube-reinforced aluminum matrix nanocomposites produced by laser powder bed fusion
- Physical, thermal, and mechanical properties of highly porous polylactic acid/cellulose nanofibre scaffolds prepared by salt leaching technique
- A comparative study on characterizations and synthesis of pure lead sulfide (PbS) and Ag-doped PbS for photovoltaic applications
- Clean preparation of washable antibacterial polyester fibers by high temperature and high pressure hydrothermal self-assembly
- Al 5251-based hybrid nanocomposite by FSP reinforced with graphene nanoplates and boron nitride nanoparticles: Microstructure, wear, and mechanical characterization
- Interlaminar fracture toughness properties of hybrid glass fiber-reinforced composite interlayered with carbon nanotube using electrospray deposition
- Microstructure and life prediction model of steel slag concrete under freezing-thawing environment
- Synthesis of biogenic silver nanoparticles from the seed coat waste of pistachio (Pistacia vera) and their effect on the growth of eggplant
- Study on adaptability of rheological index of nano-PUA-modified asphalt based on geometric parameters of parallel plate
- Preparation and adsorption properties of nano-graphene oxide/tourmaline composites
- A study on interfacial behaviors of epoxy/graphene oxide derived from pitch-based graphite fibers
- Multiresponsive carboxylated graphene oxide-grafted aptamer as a multifunctional nanocarrier for targeted delivery of chemotherapeutics and bioactive compounds in cancer therapy
- Piezoresistive/piezoelectric intrinsic sensing properties of carbon nanotube cement-based smart composite and its electromechanical sensing mechanisms: A review
- Smart stimuli-responsive biofunctionalized niosomal nanocarriers for programmed release of bioactive compounds into cancer cells in vitro and in vivo
- Photoremediation of methylene blue by biosynthesized ZnO/Fe3O4 nanocomposites using Callistemon viminalis leaves aqueous extract: A comparative study
- Study of gold nanoparticles’ preparation through ultrasonic spray pyrolysis and lyophilisation for possible use as markers in LFIA tests
- Review Articles
- Advance on the dispersion treatment of graphene oxide and the graphene oxide modified cement-based materials
- Development of ionic liquid-based electroactive polymer composites using nanotechnology
- Nanostructured multifunctional electrocatalysts for efficient energy conversion systems: Recent perspectives
- Recent advances on the fabrication methods of nanocomposite yarn-based strain sensor
- Review on nanocomposites based on aerospace applications
- Overview of nanocellulose as additives in paper processing and paper products
- The frontiers of functionalized graphene-based nanocomposites as chemical sensors
- Material advancement in tissue-engineered nerve conduit
- Carbon nanostructure-based superhydrophobic surfaces and coatings
- Functionalized graphene-based nanocomposites for smart optoelectronic applications
- Interfacial technology for enhancement in steel fiber reinforced cementitious composite from nano to macroscale
- Metal nanoparticles and biomaterials: The multipronged approach for potential diabetic wound therapy
- Review on resistive switching mechanisms of bio-organic thin film for non-volatile memory application
- Nanotechnology-enabled biomedical engineering: Current trends, future scopes, and perspectives
- Research progress on key problems of nanomaterials-modified geopolymer concrete
- Smart stimuli-responsive nanocarriers for the cancer therapy – nanomedicine
- An overview of methods for production and detection of silver nanoparticles, with emphasis on their fate and toxicological effects on human, soil, and aquatic environment
- Effects of chemical modification and nanotechnology on wood properties
- Mechanisms, influencing factors, and applications of electrohydrodynamic jet printing
- Application of antiviral materials in textiles: A review
- Phase transformation and strengthening mechanisms of nanostructured high-entropy alloys
- Research progress on individual effect of graphene oxide in cement-based materials and its synergistic effect with other nanomaterials
- Catalytic defense against fungal pathogens using nanozymes
- A mini-review of three-dimensional network topological structure nanocomposites: Preparation and mechanical properties
- Mechanical properties and structural health monitoring performance of carbon nanotube-modified FRP composites: A review
- Nano-scale delivery: A comprehensive review of nano-structured devices, preparative techniques, site-specificity designs, biomedical applications, commercial products, and references to safety, cellular uptake, and organ toxicity
- Effects of alloying, heat treatment and nanoreinforcement on mechanical properties and damping performances of Cu–Al-based alloys: A review
- Recent progress in the synthesis and applications of vertically aligned carbon nanotube materials
- Thermal conductivity and dynamic viscosity of mono and hybrid organic- and synthetic-based nanofluids: A critical review
- Recent advances in waste-recycled nanomaterials for biomedical applications: Waste-to-wealth
- Layup sequence and interfacial bonding of additively manufactured polymeric composite: A brief review
- Quantum dots synthetization and future prospect applications
- Approved and marketed nanoparticles for disease targeting and applications in COVID-19
- Strategies for improving rechargeable lithium-ion batteries: From active materials to CO2 emissions